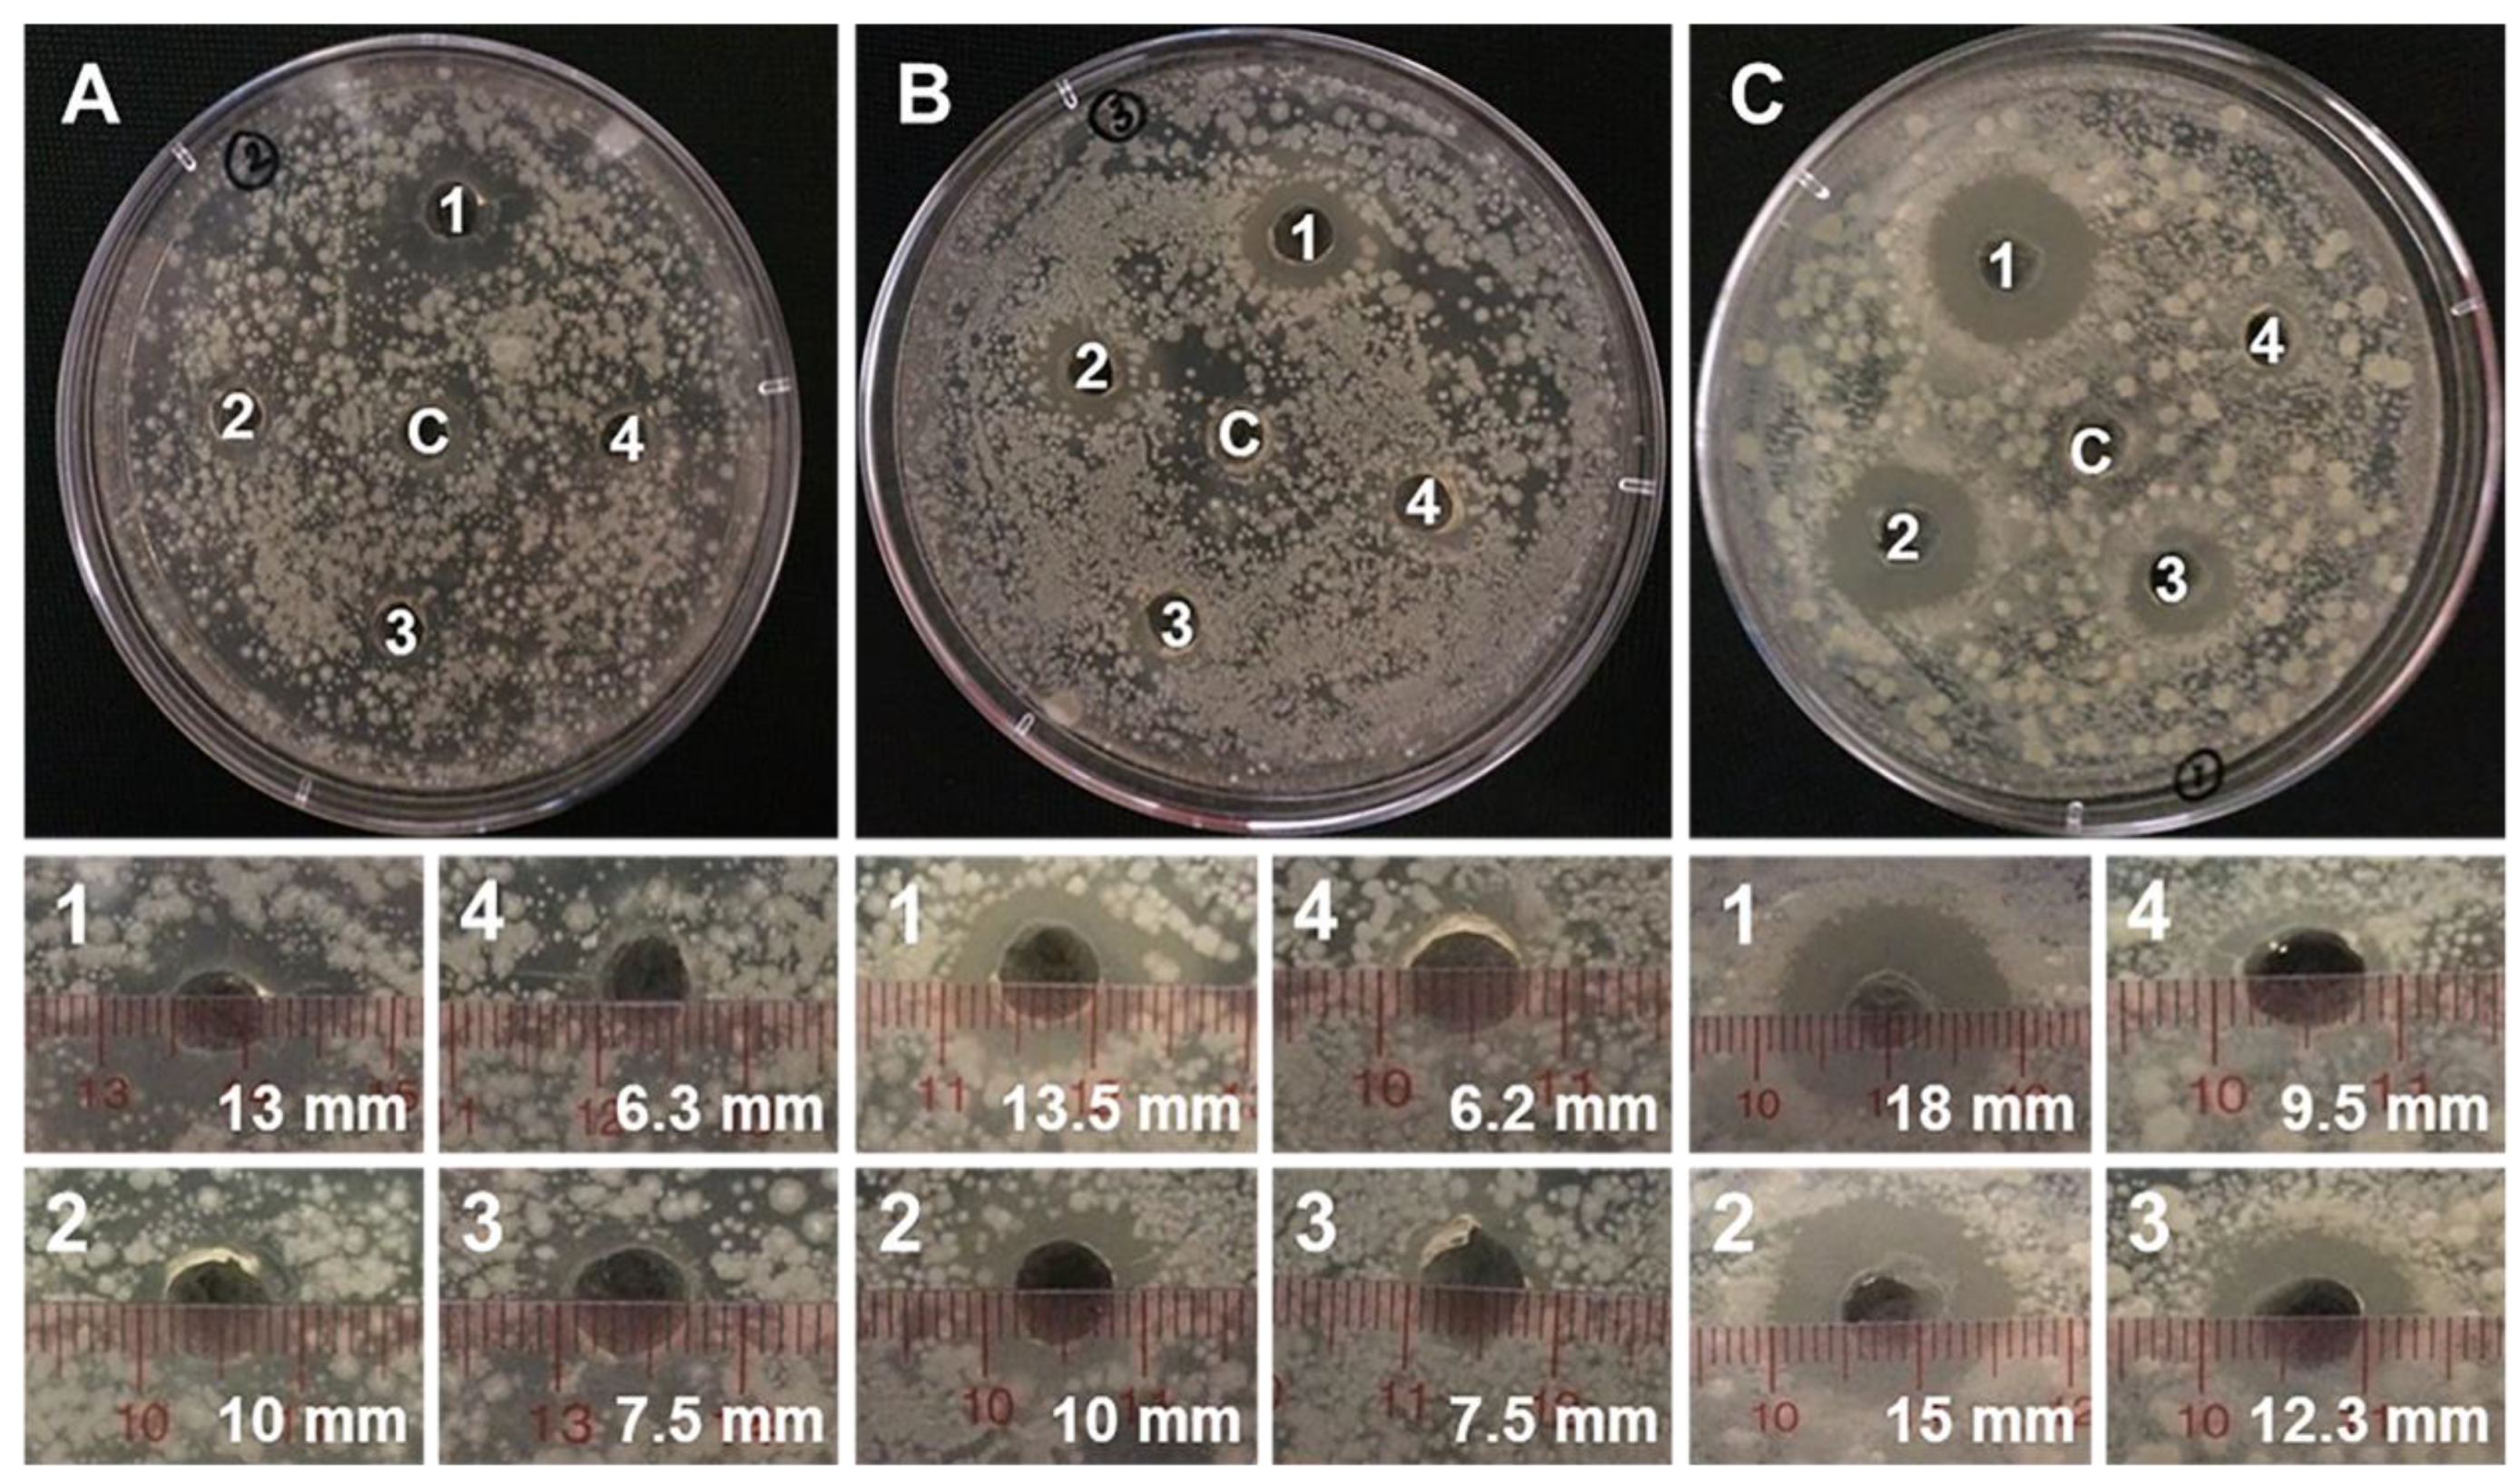
Materials 12 01446 g008 Materials 12 01446 g008

Origanum majorana L. Essential Oil-Associated Polymeric Nano Dendrimer for Antifungal Activity against Phytophthora infestans
Abstract
1. Introduction
2. Materials and Methods
2.1. Materials
2.2. Methods
2.2.1. Preparation of PAMAM G4.0 Dendrimer
2.2.2. Characteristics of Dendrimer PAMAM G4.0
2.2.3. Evaluation of the Composition of Marjoram Essential Oil
2.2.4. Synthesis of PAMAM G4.0 Combining Marjoram Essential Oil
2.2.5. Characterization of Oil/PAMAM G4.0
2.2.6. Agar diffusion method
3. Results and Discussion
3.1. Chemical Structure of Synthesized Dendrimer PAMAM G4.0
3.2. Characteristics of PAMAM G4.0 and Oil/PAMAM G4.0
3.3. Evaluation of the Composition of Marjoram Essential Oil
3.4. FT-IR Analysis
3.5. TGA Analysis
3.6. Antifungal Experiment
4. Conclusions
Author Contributions
Funding
Conflicts of Interest
References
- Genova, C.; Weinberger, K.; Chanthasombath, T.; Inthalungdsee, B.; Sanatem, K.; Somsak, K. Postharvest Loss in the Supply Chain for Vegetables: The Case of Tomato, Yardlong Bean, Cucumber and Chili in Lao PDR; AVRDC: Shanhau, Taiwan, 2006. [Google Scholar]
- Thanh, D.; Tarn, L.; Hanh, N.; Tuyen, N.; Srinivasan, B.; Lee, S.-Y.; Park, K.-S. Biological Control of Soilborne Diseases on Tomato, Potato and Black Pepper by Selected PGPR in the Greenhouse and Field in Vietnam. Plant Pathol. J. 2009, 25, 263–269. [Google Scholar] [CrossRef]
- Deans, S.G.; Svoboda, K.P. The antimicrobial properties of marjoram (Origanum majorana L.) Volatile Oil. Flavour Fragr. J. 1990, 5, 187–190. [Google Scholar] [CrossRef]
- Busatta, C.; Vidal, R.; Popiolski, A.; Mossi, A.; Dariva, C.; Rodrigues, M.; Corazza, F.; Corazza, M.; Oliveira, J.V.; Cansian, R.; et al. Application of Origanum majorana L. essential oil as an antimicrobial agent in sausage. Food Microbiol. 2008, 25, 207–211. [Google Scholar] [CrossRef] [PubMed]
- Woloshuk, C.P. Pathogen-Induced Proteins with Inhibitory Activity toward Phytophthora infestans. Plant Cell 1991, 3, 619–628. [Google Scholar]
- Van Der Vossen, E.; Sikkema, A.; Hekkert, B.T.L.; Gros, J.; Stevens, P.; Muskens, M.; Wouters, D.; Pereira, A.; Stiekema, W.; Allefs, S. An ancient R gene from the wild potato species Solanum bulbocastanum confers broad-spectrum resistance to Phytophthora infestans in cultivated potato and tomato. Plant J. 2003, 36, 867–882. [Google Scholar]
- Bilia, A.R.; Guccione, C.; Isacchi, B.; Righeschi, C.; Firenzuoli, F.; Bergonzi, M.C. Essential Oils Loaded in Nanosystems: A Developing Strategy for a Successful Therapeutic Approach. Evid.-Based Complement. Altern. Med. 2014, 2014, 1–14. [Google Scholar]
- Nguyen, D.H.; Joung, Y.K.; Choi, J.H.; Moon, H.T.; Park, K.D. Targeting ligand-functionalized and redox-sensitive heparin-Pluronic nanogels for intracellular protein delivery. Biomed. Mater. 2011, 6, 55004. [Google Scholar] [CrossRef]
- Dai, L.; Zhang, B.; Li, J.; Liu, J.; Luo, Z.; Cai, K. Redox-Responsive Nanocarrier Based on Heparin End-Capped Mesoporous Silica Nanoparticles for Targeted Tumor Therapy in Vitro and in Vivo. Langmuir 2014, 30, 7867–7877. [Google Scholar] [CrossRef] [PubMed]
- Nguyen, D.H.; Lee, J.S.; Choi, J.H.; Park, K.M.; Lee, Y.; Park, K.D. Hierarchical self-assembly of magnetic nanoclusters for theranostics: Tunable size, enhanced magnetic resonance imagability, and controlled and targeted drug delivery. Acta Biomater. 2016, 35, 109–117. [Google Scholar] [CrossRef] [PubMed]
- Yallapu, M.M.; Gupta, B.K.; Jaggi, M.; Chauhan, S.C. Fabrication of curcumin encapsulated PLGA nanoparticles for improved therapeutic effects in metastatic cancer cells. J. Colloid Interface Sci. 2010, 351, 19–29. [Google Scholar] [CrossRef]
- Nguyen, T.L.; Nguyen, T.H.; Nguyen, C.K.; Nguyen, D.H. Redox and pH Responsive Poly (Amidoamine) Dendrimer-Heparin Conjugates via Disulfide Linkages for Letrozole Delivery. BioMed Int. 2017, 2017, 1–7. [Google Scholar] [CrossRef]
- Thanh, V.M.; Nguyen, T.H.; Tran, T.V.; Ngoc, U.-T.P.; Ho, M.N.; Nguyen, T.T.; Chau, Y.N.T.; Le, V.T.; Tran, N.Q.; Nguyen, C.K.; et al. Low systemic toxicity nanocarriers fabricated from heparin-mPEG and PAMAM dendrimers for controlled drug release. Mater. Sci. Eng. C 2018, 82, 291–298. [Google Scholar] [CrossRef] [PubMed]
- Fréchet, J.M.J.; Tomalia, D.A. Dendrimers and Other Dendritic Polymers: Frechet/Dendrimers; John Wiley & Sons, Ltd.: Chichester, UK, 2001. [Google Scholar]
- Nguyen, T.T.C.; Nguyen, C.K.; Nguyen, T.H.; Tran, N.Q. Highly lipophilic pluronics-conjugated polyamidoamine dendrimer nanocarriers as potential delivery system for hydrophobic drugs. Mater. Sci. Eng. C 2017, 70, 992–999. [Google Scholar] [CrossRef] [PubMed]
- Tran, N.Q.; Nguyen, C.K. Biocompatible nanomaterials based on dendrimers, hydrogels and hydrogel nanocomposites for use in biomedicine. Adv. Sci. Nanosci. Nanotechnol. 2017, 8, 15001. [Google Scholar]
- Chen, C.Z.; Cooper, S.L. Interactions between dendrimer biocides and bacterial membranes. Biomaterials 2002, 23, 3359–3368. [Google Scholar] [CrossRef]
- Chen, C.Z.; Beck-Tan, N.C.; Dhurjati, P.; Van Dyk, T.K.; LaRossa, R.A.; Cooper, S.L. Quaternary Ammonium Functionalized Poly(propylene imine) Dendrimers as Effective Antimicrobials: Structure–Activity Studies. Biomacromolecules 2000, 1, 473–480. [Google Scholar] [CrossRef] [PubMed]
- Winnicka, K.; Sosnowska, K.; Wieczorek, P.; Sacha, P.T.; Tryniszewska, E. Poly(amidoamine) Dendrimers Increase Antifungal Activity of Clotrimazole. Biol. Pharm. Bull. 2011, 34, 1129–1133. [Google Scholar] [CrossRef] [PubMed]
- Winnicka, K.; Wroblewska, M.; Wieczorek, P.; Sacha, P.T.; Tryniszewska, E. Hydrogel of Ketoconazole and PAMAM Dendrimers: Formulation and Antifungal Activity. Molecules 2012, 17, 4612–4624. [Google Scholar] [CrossRef]
- Jose, J.; Charyulu, R.N. Prolonged drug delivery system of an antifungal drug by association with polyamidoamine dendrimers. Int. J. Pharm. Investig. 2016, 6, 123–127. [Google Scholar] [CrossRef] [PubMed]
- Paomephan, P.; Assavanig, A.; Chaturongakul, S.; Cady, N.C.; Bergkvist, M.; Niamsiri, N. Insight into the antibacterial property of chitosan nanoparticles against Escherichia coli and Salmonella Typhimurium and their application as vegetable wash disinfectant. Food Control 2018, 86, 294–301. [Google Scholar] [CrossRef]
- Shankar, S.; Pangeni, R.; Park, J.W.; Rhim, J.-W. Preparation of sulfur nanoparticles and their antibacterial activity and cytotoxic effect. Mater. Sci. Eng. C 2018, 92, 508–517. [Google Scholar] [CrossRef]
- Agnihotri, S.A.; Mallikarjuna, N.N.; Aminabhavi, T.M. Recent advances on chitosan-based micro- and nanoparticles in drug delivery. J. Control. Release 2004, 100, 5–28. [Google Scholar] [CrossRef] [PubMed]
- Sharma, S. Enhanced antibacterial efficacy of silver nanoparticles immobilized in a chitosan nanocarrier. Int. J. Boil. Macromol. 2017, 104, 1740–1745. [Google Scholar] [CrossRef]
- Teow, H.M.; Zhou, Z.; Najlah, M.; Yusof, S.R.; Abbott, N.J.; D’Emanuele, A. Delivery of paclitaxel across cellular barriers using a dendrimer-based nanocarrier. Int. J. Pharm. 2013, 441, 701–711. [Google Scholar] [CrossRef] [PubMed]
- Choudhary, S.; Gupta, L.; Rani, S.; Dave, K.; Gupta, U.; Gupta, D.U. Impact of Dendrimers on Solubility of Hydrophobic Drug Molecules. Front. Pharmacol. 2017, 8, 261. [Google Scholar] [CrossRef]
- Voltan, A.R.; Quindós, G.; Alarcón, K.P.M.; Fusco-Almeida, A.M.; Mendes-Giannini, M.J.S.; Chorilli, M.; Mendes-Giannini, M.J. Fungal diseases: Could nanostructured drug delivery systems be a novel paradigm for therapy? Int. J. Nanomed. 2016, 11, 3715–3730. [Google Scholar] [CrossRef]
- Bondaryk, M.; Staniszewska, M.; Zielińska, P.; Urbańczyk-Lipkowska, Z. Natural antimicrobial peptides as inspiration for design of a new generation antifungal compounds. J. Fungi 2017, 3, 46. [Google Scholar] [CrossRef]

| Concentration (ppm) | Diameter of Inhibition Zone (d. mm) | |
|---|---|---|
| Marjoram Essential Oil | PAMAM G4.0 | |
| 500 | - | 6.33 ± 0.33 |
| 1000 | - | 7.50 ± 0.33 |
| 2000 | - | 10.00 ± 0.33 |
| 5000 | - | 12.50 ± 0.50 |
| - | 500 | 6.16 ± 0.34 |
| - | 1000 | 7.50 ± 0.50 |
| - | 2000 | 10.00 ± 0.33 |
| - | 5000 | 12.00 ± 0.50 |
| 500 | 500 | 9.50 ± 0.50 |
| 1000 | 1000 | 12.33 ± 0.33 |
| 2000 | 2000 | 15.00 ± 0.00 |
| 5000 | 5000 | 18.00 ± 0.50 |
© 2019 by the authors. Licensee MDPI, Basel, Switzerland. This article is an open access article distributed under the terms and conditions of the Creative Commons Attribution (CC BY) license (http://creativecommons.org/licenses/by/4.0/).
Share and Cite
Thanh, V.M.; Bui, L.M.; Bach, L.G.; Nguyen, N.T.; Thi, H.L.; Hoang Thi, T.T. Origanum majorana L. Essential Oil-Associated Polymeric Nano Dendrimer for Antifungal Activity against Phytophthora infestans. Materials 2019, 12, 1446. https://doi.org/10.3390/ma12091446
Thanh VM, Bui LM, Bach LG, Nguyen NT, Thi HL, Hoang Thi TT. Origanum majorana L. Essential Oil-Associated Polymeric Nano Dendrimer for Antifungal Activity against Phytophthora infestans. Materials. 2019; 12(9):1446. https://doi.org/10.3390/ma12091446
Chicago/Turabian StyleThanh, Vu Minh, Le Minh Bui, Long Giang Bach, Ngoc Tung Nguyen, Hoa Le Thi, and Thai Thanh Hoang Thi. 2019. "Origanum majorana L. Essential Oil-Associated Polymeric Nano Dendrimer for Antifungal Activity against Phytophthora infestans" Materials 12, no. 9: 1446. https://doi.org/10.3390/ma12091446
APA StyleThanh, V. M., Bui, L. M., Bach, L. G., Nguyen, N. T., Thi, H. L., & Hoang Thi, T. T. (2019). Origanum majorana L. Essential Oil-Associated Polymeric Nano Dendrimer for Antifungal Activity against Phytophthora infestans. Materials, 12(9), 1446. https://doi.org/10.3390/ma12091446





